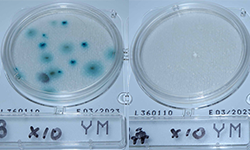
オゾンラボ169/酒樽の殺菌実験

オゾンラボトップに戻る
-
FILE178
![オゾンラボ178/PETボトル粉砕チップの脱色]()
PETボトル粉砕チップの脱色
2024.10.16
詳細へ
-
FILE177
![オゾンラボ177/吸気の臭気対策におけるオゾン分解触媒の効果実証]()
吸気の臭気対策におけるオゾン分解触媒の効果実証
2024.09.17
詳細へ
-
FILE176
![オゾンラボ176/鋳造工程で発生する臭気の脱臭実験]()
鋳造工程で発生する臭気の脱臭実験
2024.08.13
詳細へ
-
FILE175
![オゾンラボ175/バターオイル臭の脱臭実験]()
バターオイル臭の脱臭実験
2024.07.25
詳細へ
-
FILE174
![オゾンラボ174/ケミカル排水の脱臭実験]()
ケミカル排水の脱臭実験
2024.06.18
詳細へ
-
FILE173
![オゾンラボ173/オゾン殺菌によるシークヮーサー果汁の品質向上]()
オゾン殺菌によるシークヮーサー果汁の品質向上
2024.05.08
詳細へ
-
FILE172
![オゾンラボ172/樹脂バインダー定着工程で発生する臭気の脱臭]()
樹脂バインダー定着工程で発生する臭気の脱臭
2024.04.09
詳細へ
-
FILE171
![オゾンラボ171/鋳造工程で発生するアンモニア臭の脱臭]()
鋳造工程で発生するアンモニア臭の脱臭
2024.03.13
詳細へ
-
FILE170
![オゾンラボ170/車載オゾン水散水システム]()
車載オゾン水散水システム
2024.02.15
詳細へ
-
FILE169
![オゾンラボ169/酒樽の殺菌実験]()
酒樽の殺菌実験
2024.01.11
詳細へ
-
FILE168
![オゾンラボ168/高い水温でのオゾン水濃度の減衰]()
高い水温でのオゾン水濃度の減衰
2023.12.15
詳細へ
-
FILE167
![オゾンラボ167/河川に残留する化学肥料(亜硝酸態窒素)のオゾン分解]()
河川に残留する化学肥料(亜硝酸態窒素)のオゾン分解
2023.11.21
詳細へ

オゾンラボについて
オゾンラボは、和歌山県にある三協エアテックの研究室です。
臭気や水質、殺菌に関するお客様の課題を解決するため、日々、オゾンを活用した実験に基づく、システム開発および新技術の研究を行っています。
当社のノウハウを駆使してご満足いただける解決策を提案させていただきますので、お困りの課題がありましたら、ぜひお問合せください。
- トップ
- オゾンラボ